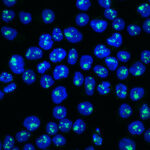

Around 5200 people are diagnosed with a form of leukaemia in Australia each year. An estimated 1500 of these cases are acute – meaning the blood cancer appears suddenly and grows quickly.
Blood cancers like leukaemia are notoriously difficult to treat in adults, with 50% of Australian patients relapsing after the first round of chemotherapy and subsequently becoming resistant to further treatments.
Associate Professor Ashley Ng, a corresponding author on the paper, said this presented a unique treatment challenge for these blood cancers and highlighted the urgent need for new therapeutics.
“About 135,000 people live with a blood cancer or blood disorder in Australia, with 16 people dying every day from the disease,” Assoc Prof Ng, a WEHI researcher and clinical haematologist at the Peter MacCallum Cancer Centre and Royal Melbourne Hospital, said.
“Despite the medical advancements made in the cancer field over the years, the incidence of blood cancer has grown by 47% in the past decade.
“The best way to enhance treatment options for patients is to continually improve our understanding of how leukaemia cancers behave and what drives their growth.
“Our new research has identified two proteins that are critical for the development of B-cell acute lymphoblastic leukaemia, expanding our knowledge into how these cancers can form.
“By uncovering this new vulnerability in leukaemia formation, we hope to exploit the findings for therapeutic benefit and also apply them to other forms of the disease.”
The research is published in the journal Science Advances.